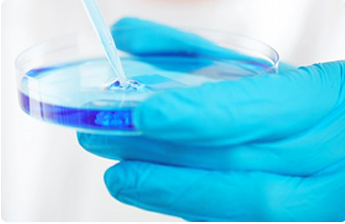

走进班森科技
Walked into Benson
班森坚持以皮肤科理论科学为基础,以安全有效的成分为源头,用精准高效的产品,提供独到的班森医美护肤解决方案,使肌肤恢复健康美丽状态,更坚定的提升服务品质,让医美以更完美的方式触达每一位爱美之人。



研发实力
研发中心自成立以来,先后与兰州大学等国内多所大学长期合作,联合建立创新研究院,取得了多项技术成果。以“高效性丶安全性丶稳定性”为产品开发原则,满足消费者对天然丶绿色美容护肤化妆产品的需求。先后获得多项发明专利,另外,业内率先成立护肤研究中心,建立大数据实验云系统,为客户提供准确的数据支撑与安全的临床实验验证。
10位
高级工程师
30位
研发人员

2000+
成熟配方+

公司注重于高新科技的研发,拥有一支以博士丶研究生丶本专科以上学历为核心的高所知专业研发团队,企业掌舵人拥有十多年科研背景,为企业植入身后的科研技术基因。且团队中大多数曾参与国际一线品牌产品的开发与研究,多年从事天然产物的提取丶护肤品配方等相关研究,涉及医学抗衰垫皮肤管理丶生物科技等多个领域,积累了丰厚的研究成果和成熟的技术方法,能有效解决活动开发过程中所遇到的技术难题。

实验室

乳化间

实验室2

设备3